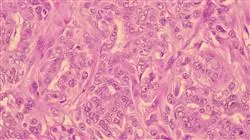
##IMAGE##

Qualificação universitária
A maior faculdade de medicina do mundo”
Porquê estudar no TECH?
Este Programa avançado em Anatomia Patologia Feminino irá gerar uma sensação de segurança no desempenho de sua profissão, o que lhe ajudará a oferecer um serviço de qualidade aos seus pacientes"
Atualmente, tem havido muitas pesquisas sobre tratamentos de ponta e avanços para aumentar a capacidade de eliminar malignidades emergentes, como os anticorpos anti-PD1 e anti-PDL1, que estão demonstrando cada vez mais eficácia nos resultados dos pacientes.
Os profissionais da área de oncologia precisam atualizar constantemente seus conhecimentos sobre o tratamento do câncer, para poder oferecer aos pacientes o tratamento mais adequado com base em suas reais necessidades.
Este Programa avançado de Patologia Anatômica Feminina lhe dá a oportunidade de se especializar no tratamento de câncer em mulheres, com o objetivo de se tornar um excelente profissional no tratamento de doenças específicas do sexo feminino.
Este programa lhe permitirá desenvolver as competências, habilidades e destrezas que são propícias ao desempenho da profissão, gerando maior valor agregado ao seu desempenho profissional.
O programa foi desenvolvido por uma gama dos profissionais mais prestigiados na área de oncologia, que contribuem para cada módulo com suas próprias experiências profissionais, os avanços mais notáveis e os tratamentos mais eficazes em cada uma das especialidades oncológicas sobre as quais se concentra. Além disso, inclui 10 Masterclasses ministradas por um diretor internacional convidado especializado na área de patologia. Uma grande oportunidade de especialização em Anatomia Patologia Feminino com aqueles que mais conhecem sobre este assunto
Atualize seus conhecimentos por meio deste programa que inclui 10 masterclasses de alto nível ministradas por um renomado especialista internacional”
Este Programa avançado de Anatomia Patológica Feminina conta com o conteúdo científico mais completo e atualizado do mercado. Suas principais características são:
- O desenvolvimento de mais de 75 casos clínicos apresentados por especialistas em Anatomia Patológica. Feminino
- O conteúdo gráfico, esquemático e extremamente útil, fornece informações científicas e práticas sobre as disciplinas essenciais para o exercício da profissão
- Novidades sobre Anatomia Patológica Feminino
- Contém exercícios práticos em que o processo de autoavaliação é realizado para melhorar a de aprendizagem
- Ênfase particular em metodologias inovadoras em Anatomia Patológica Feminino
- Lições teóricas, perguntas aos especialistas, fóruns de discussão sobre assuntos controversos e trabalhos de reflexão individuais
- Acesso a todo o conteúdo desde qualquer dispositivo, fixo ou portátil, com conexão à Internet
Este Programa avançado é o melhor investimento que você pode fazer na seleção de um curso por duas razões: além de atualizar seus conhecimentos sobre Anatomia Patológica Feminina, você obterá um certificado da TECH Universidade Tecnologica"
O corpo docente do curso conta com profissionais do setor, que transferem toda a experiência adquirida ao longo de suas carreiras para esta capacitação, além de especialistas reconhecidos de instituições de referência e universidades de prestígio.
O conteúdo multimídia, desenvolvido com a mais recente tecnologia educacional, permitirá ao profissional uma aprendizagem contextualizada, ou seja, realizada através de um ambiente simulado, proporcionando uma capacitação imersiva e programada para praticar diante de situações reais.
A estrutura deste programa se concentra na Aprendizagem Baseada em Problemas, através da qual o profissional deverá resolver as diferentes situações de prática profissional que surgirem ao longo do curso acadêmico. Para isso, o profissional contará com a ajuda de um inovador sistema de vídeo interativo, realizado por especialistas reconhecidos nesta área.
Aumente seu desempenho profissional e melhore a qualidade de vida de seus pacientes"

Aproveite a oportunidade para conhecer os últimos avanços da Atualização em Patologia Feminino e seja mais eficaz em sua prática diária"
Plano de estudos
A estrutura dos conteúdos foi elaborada por uma equipe formada pelos melhores profissionais do setor anatomia patológica com com ampla experiência e reconhecido prestígio na profissão Com o apoio de um vasto número de casos revisados, estudados e diagnosticados, e com grande conhecimento das novas tecnologias aplicadas ao diagnóstico anatomopatológico. A partir do módulo 1, os alunos verão seus conhecimentos ampliados, o que permitirá se desenvolver profissionalmente, sabendo que podem contar com o apoio de uma equipe de especialistas.

Este Programa avançado de Anatomia Patologias Feminino conta com o conteúdo científico mais completo e atualizado do mercado”
Módulo 1. Câncer. Visão geral Fatores de risco
1.1. Introdução
1.2. Generalidades das neoplasias malignas
1.2.1. Nomenclatura
1.2.2. Características
1.2.3. Vias de disseminação de metástases
1.2.4. Fatores de prognósticos
1.3. Epidemiologia do câncer
1.3.1. Incidência
1.3.2. Prevalência
1.3.3. Distribuição geográfica
1.3.4. Fatores de risco
1.3.5. Prevenção
1.3.6. Diagnóstico precoce
1.4. Agentes mutagênicos
1.4.1. Ambientais
1.4.2. Laborais
1.4.3. Substâncias tóxicas nos alimentos
1.5. Agentes biológicos e câncer
1.5.1. Vírus ARN
1.5.2. Vírus ADN
1.5.2.1. H. pylori
1.6. Predisposição genética
1.6.1. Genes associados ao câncer
1.6.2. Genes de susceptibilidade
1.6.2.1. Tumores de mama
1.6.2.2. Tumores pulmonares
1.6.2.3. Tumores de tireoide
1.6.2.4. Tumores de cólon
1.6.2.5. Tumores da pele
1.6.2.6. Tumores de ossos
1.6.2.7. Tumores no pâncreas
1.6.2.8. Neuroblastoma
1.7. Aspectos clínicos das neoplasias malignas
1.7.1. Princípios básicos
1.8. Estadiamento de doenças neoplásicas
1.8.1. Princípios Básicos
Módulo 2. Bases moleculares do câncer
2.1. Introdução às bases moleculares do câncer
2.1.1. Genes e genoma
2.1.1.1. Principais vias de sinalização celular
2.1.1.2. Crescimento e proliferação celular
2.1.1.3. Morte celular. Necrose e apoptose
2.1.2. Mutações
2.1.2.1. Tipos de mutações. Frameshift; InDels, Translocações, SNV; Missense, nonsense, CNV, Driver x Passenger
2.1.2.2. Agentes causadores de mutações
2.1.2.2.1. Agentes biológicos e câncer
2.1.2.3. Mecanismos de reparo de mutações
2.1.2.4. Mutações com variantes patológicas e não patológicas
2.1.3. Principais avanços na medicina de precisão
2.1.3.1. Biomarcadores tumorais
2.1.3.2. Oncogenes e genes supressores do tumor
2.1.3.3. Biomarcadores diagnósticos
2.1.3.3.1. Resistência
2.1.3.3.2. Prognóstico
2.1.3.3.3. Farmacogenômica
2.1.3.4. Epigenética do câncer
2.1.4. Principais técnicas em biologia molecular do câncer
2.1.4.1. Citogenética e FISH
2.1.4.2. Qualidade do extrato de DNA
2.1.4.3. Biópsia líquida
2.1.4.4. PCR como uma ferramenta molecular básica
2.1.4.5. Sequenciamento, NGS
Módulo 3. Tumores da mama feminina
3.1. Epidemiologia do câncer de mama
3.1.1. Distribuição global
3.1.2. Incidência e prevalência
3.1.3. Fatores de risco
3.1.4. Diagnóstico precoce
3.2. O circuito de diagnóstico do câncer
3.2.1. Trabalho multidisciplinar
3.2.2. Radiologia e anatomia patológica da mama
3.2.3. Diagnóstico por biópsia com agulha grossa e aspiração a vácuo
3.3. Informações gerais sobre a mama
3.3.1. Expressão dos receptores hormonais
3.4. Aspectos clínicos das lesões precursoras do câncer de mama
3.4.1. Lesões B3
3.4.2. Diagnóstico: painel imunohistoquímico
3.4.3. Tratamento
3.4.3.1. Excisão
3.4.3.2. Bless
3.4.3.3. Vigilância ativa
3.4.3.4. Hormonoterapia
3.5. Carcinoma ductal e carcinoma lobular, invasivos
3.5.1. Aspectos clínico e radiológicos
3.5.2. Comportamento biológico
3.5.3. Estadiamento do câncer hereditário
3.5.4. Grupo de prognóstico
3.5.5. Perfil biológico do câncer de mama
3.5.5.1. Receptores hormonais, ki67 e Her2 (diagnóstico imunohistoquímico - HIS)
3.5.6. Papel da p53 e do bcl2 no câncer de mama
3.5.7. Novos alvos terapêuticos
3.5.7.1. PD1/PDL-1
3.6. Avaliação da patologia mamária pós-neoadjuvante
3.6.1. O gânglio sentinela
3.6.1.1. Diagnóstico pré e pós-neoadjuvante
3.6.1.1.1. Método OSNA
3.6.1.1.2. Corte congelado
3.7. Manejo axilar
3.7.1. Preservação Axilar x Linfadenectomia
Módulo 4. Tumores do trato genitivo urinário
4.1. Ovário (Dra. María Serrano)
4.1.1. Epidemiologia
4.1.1.1. Câncer de ovário hereditário
4.1.2. Classificação
4.1.2.1. Atualização e conceitos
4.1.2.2. Tumores da superfície epitelial do ovário
4.1.2.3. Patogênese
4.1.2.4. Subtipos histológicos
4.1.2.5. Inmunohistoquímica
4.1.2.6. Características moleculares
4.1.3. Tumores do estroma do ovário
4.1.3.1. Subtipos histológicos
4.1.3.2. Inmunohistoquímica
4.1.3.3. Características moleculares
4.1.4. Tumores de células germinativas do ovário
4.1.4.1. Subtipos histológicos
4.1.4.2. Inmunohistoquímica
4.1.4.3. Características moleculares
4.1.5. Imunoterapia
4.1.5.1. O papel do patologista nos alvos terapêuticos para o câncer de ovário
4.2. Vulva (Dra. Sara Soto)
4.2.1. Lesões precursoras de carcinoma da vulva
4.2.1.1. Nova terminologia
4.2.2. Tipos de carcinomas epiteliais da vulva
4.2.2.1. Atualização
4.2.3. Classificação TNM / FIGO
4.2.3.1. Atualização
4.2.4. Outras neoplasias malignas
4.3. Útero (Dra. Sara Soto)
4.3.1. Classificação OMS
4.3.1.1. Atualização
4.3.2. Tipos de carcinomas epiteliais de útero
4.3.2.1. Inmunohistoquímica
4.3.2.2. Aspectos moleculares
4.3.3. Sarcomas uterinos
4.3.3.1. Atualização
4.3.4. Outras neoplasias malignas do útero
4.3.4.1. Atualização
4.3.5. Classificação TNM / FIGO
4.3.5.1. Atualização
4.4. Patologia da próstata e da vesícula seminal. Dra. Josefa Herrero)
4.4.1. Histopatologia da próstata
4.4.1.1. Lesões não tumorais
4.4.1.2. Lesões “pré-malignas”
4.4.1.3. Lesões malignas da próstata
4.4.2. Neoplasia da vesícula seminal
4.4.3. Aspectos gerais do processamento histológico, histoquímica e imunohistoquímica
4.4.4. Base da patologia molecular da próstata, medicina de precisão e qualidade
Módulo 5. Diagnóstico citológico de lesões malignas
5.1. Introdução à citopatologia (Arte e CIÊNCIA)
5.1.1. Perspectiva histórica
5.1.2. Conceitos práticos
5.1.2.1. Manejo
5.1.2.2. Coloração
5.1.3. Conceitos básicos citomorfológicos
5.2. Citologia esfoliativa
5.2.1. Citologia Ginecológica - Sistema de Bethesda
5.2.2. Citologia da urina - Sistema Paris
5.2.3. Citologia de fluidos corporais
5.3. Punção aspirativa com agulha fina superficial
5.3.1. Introdução
5.3.1.1. Aspectos práticos
5.3.2. PAAF da tireoide e glândula salivar
5.3.3. PAAF de mama
5.3.4. PAAF de partes moles e osso
5.4. Punção aspirativa com agulha fina profunda
5.4.1. Introdução - ROSE (Rapid on site evaluation)
5.4.1.1. PAAF de pulmão e mediastino
5.4.1.2. PAAF de pâncreas
5.4.1.3. PAAF de linfonodos
5.5. Diagnóstico diferencial em citopatologia
5.5.1. Principais padrões citomorfológicos
5.5.2. Imunocitohistoquímica
5.5.3. Ciclopatologia molecular
5.6. O papel do citopatologista no tratamento do câncer
5.6.1. Estudos de biomarcadores em amostras citológicas
5.6.2. Imunoterapia e o papel da citopatologia
5.6.3. Desafios e novas perspectivas

Aproveite a oportunidade para se atualizar sobre os últimos avanços na área e aplicá-los à sua prática diária"
Programa Avançado de Anatomia Patológica Feminina
Explore a Anatomia Patológica Feminina com Especialistas Universitários na TECH Universidade Tecnológica! Você é apaixonado pelo estudo minucioso e preciso do corpo humano? Deseja aprofundar-se no fascinante mundo da anatomia patológica feminina? Então, este programa virtual é para você! Na TECH Universidade Tecnológica, oferecemos a oportunidade única de mergulhar no Programa Avançado de Anatomia Patológica Feminina, projetado para que você possa desenvolver habilidades sólidas e conhecimentos especializados no conforto de sua casa. Durante o programa, você analisará de forma detalhada as doenças e transtornos específicos que afetam o sistema reprodutivo feminino, desde o diagnóstico até o tratamento. Você se aprofundará na anatomia e fisiologia dos órgãos femininos, bem como nos métodos de avaliação e análise de amostras patológicas. Além disso, adquirirá habilidades práticas no manuseio de equipamentos e tecnologias de ponta utilizados na área.
O futuro está à sua espera e na TECH estamos aqui para ajudá-lo a alcançá-lo
Nossa equipe de professores altamente qualificada irá acompanhá-lo ao longo do programa, fornecendo uma capacitação de qualidade e experiência real no campo da anatomia patológica feminina. Esse especialistas irão guiá-lo através dos conceitos fundamentais, das técnicas mais avançadas e das últimas pesquisas na área. Você aprenderá com os melhores profissionais para se tornar um especialista! Ao concluir o programa, você receberá um certificado internacionalmente reconhecido, respaldado pela Faculdade de Medicina da TECH Universidade Tecnológica. Este certificado será uma sólida prova de sua experiência e competência em anatomia patológica feminina, abrindo portas para diversas oportunidades profissionais. Você poderá trabalhar em hospitais, clínicas, laboratórios de pesquisa e colaborar com equipes médicas multidisciplinares, contribuindo para a saúde e o bem-estar das mulheres em todo o mundo. Não perca a oportunidade de estudar na TECH e se tornar um especialista em Anatomia Patológica Feminina! Descubra um mundo fascinante, desenvolva habilidades especializadas e conheça uma área em constante crescimento. Matricule-se hoje mesmo e prepare-se para um futuro profissional promissor!







